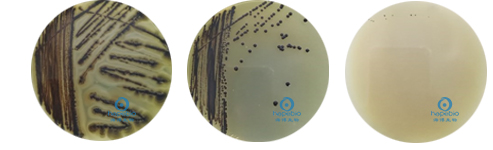

海博微信公众号
海博天猫旗舰店




一、简介
金黄色葡萄球菌(Staphylococcus aureus)是人类的一种重要病原菌,隶属于葡萄球菌属(Staphylococcus),有“嗜肉菌”的别称,是革兰氏阳性菌的代表,可引起许多严重感染。可引起局部化脓感染,也可引起肺炎、伪膜性肠炎、心包炎等,甚至败血症、脓毒症等全身感染。
典型的金黄色葡萄球菌为球形,直径0.8μm左右,显微镜下排列成葡萄串状。革兰阳性菌,无芽孢、无鞭毛,体外培养时一般不形成荚膜,但少数菌株的细胞壁外层可见有荚膜样粘液物质。在某些化学物质(青霉素)作用下,可裂解或变成L型。
金黄色葡萄球菌营养要求不高,在普通培养基上生长良好,需氧或兼性厌氧,最适生长温度37℃,最适生长pH7.4。平板上菌落厚、有光泽、圆形凸起,直径1-2mm。血平板上菌落周围形成透明的溶血环。
金黄色葡萄球菌有高度的耐盐性,可在10%-15%NaCl肉汤中生长。耐热性强,加热70℃1h,80℃30min不被杀死;耐低温,在冷冻食品中不易死亡;耐高渗,在含有50%-66%蔗糖或15%以上食盐食品中才可被抑制,能在15%NaCl和40%胆汁中生长。金黄色葡萄球菌具有较强的抵抗力,对磺胺类药物敏感性低,但对青霉素、红霉素等高度敏感。
二、检测要求
食品、药品、化妆品等相关标准中,均要求对金黄色葡萄球菌进行检测。通常情况下,仅要求对样品中有无金黄色葡萄球菌进行定性判断,但有时候也会有定量检测的要求。有关金黄色葡萄球菌定性检测的操作,可参考:金黄色葡萄球菌的简单介绍 点击查看,本文主要对金黄色葡萄球菌的定量检测方法进行讨论。
三、检验方法
参考标准《GB4789.10-2016 食品安全国家标准 食品微生物学检验 金黄色葡萄球菌检验》
1.平板计数法
1.1 对于金黄色葡萄球菌含量较多的样品,通常采用平板计数法进行定量检测。其检测程序如下(图1):
图1 金黄色葡萄球菌平板计数法检验程序
1.2 金黄色葡萄球菌及常见菌在Baird-Parker平板上的菌落特征
金黄色葡萄球菌在Baird-Parker平板上呈圆形,表面光滑、凸起、湿润、菌落直径为2mm~3mm,颜色呈灰黑色至黑色,有光泽,常有浅色(非白色)的边缘,周围绕以不透明圈(沉淀),其外常有一清晰带。当用接种针触及菌落时具有黄油样黏稠感。有时可见到不分解脂肪的菌株,除没有不透明圈和清晰带外,其他外观基本相同。
从长期贮存的冷冻或脱水食品中分离的菌落,其黑色常较典型菌落浅些,且外观可能较粗糙,质地较干燥。同属的表皮葡萄球菌在Baird-Parker平板上,也为黑色菌落,但无浑浊带和透明圈(如图2)。
| 金黄色葡萄球菌 | 表皮葡萄球菌 |
在Baird-Parker平板上,普通变形杆菌为黑色圆形菌落,有浑浊带及透明圈,浑浊带较大;奇异变形杆菌则为褐色圆形菌落,边缘绕一较小的透明带;大肠埃希氏菌则是被抑制,不能生长(如图3)
| 普通变形杆菌 | 奇异变形杆菌 | 大肠杆菌 |
1.3 鉴定
从典型菌落中至少选5个可疑菌落(小于5个全选)进行鉴定试验。分别做染色镜检,血浆凝固酶试验,同时划线接种到血平板36℃±1℃培养18h~24h后观察菌落形态,金黄色葡萄球菌菌落较大,圆形、光滑凸起、湿润、金黄色(有时为白色),菌落周围可见完全透明溶血圈。
1.4 结果计算
(1)若只有一个稀释度平板的典型菌落数在20CFU~200CFU之间,计数该稀释度平板上的典型菌落;若最低稀释度平板的典型菌落数小于20CFU,计数该稀释度平板上的典型菌落;若某一稀释度平板的典型菌落数大于200CFU,但下一稀释度平板上没有典型菌落,计数该稀释度平板上的典型菌落;若某一稀释度平板的典型菌落数大于200CFU,而下一稀释度平板上虽有典型菌落但不在20CFU~200CFU范围内,应计数该稀释度平板上的典型菌落,上面几种情况得出的菌落数,代入公式①,计算出样品中金黄色葡萄球菌的数量,进行报告。
公式①
(2)若2个连续稀释度的平板典型菌落数均在20CFU~200CFU 之间,按公式②计算。
公式②
2.MPN法
2.1 对于含金黄色葡萄球菌菌量较多的样品,通常MPN计数法进行定量检测。其检验程序如图4:
图4 金黄色葡萄球菌MPN法检验程序
2.2 与平板计数法相比,本方法在样品稀释后增加了一个增菌过程,其原因正是由于样品中金黄色葡萄球菌数量较少,需要通过选择性增菌过程让菌数增多,再进行下一步检测。
该增菌过程使用了7.5%NaCl肉汤,也是很好地利用了金黄色葡萄球菌耐高盐的特性,在有效抑制其他杂菌的同时,让金黄色葡萄球菌正常生长增殖。
2.3本步骤中的鉴定试验,与平板法基本一致,包括血平板划线、血浆凝固试验并借助革兰氏染色、镜检等方法(具体做法和特征,均可参考金黄色葡萄球菌定性检验的简单介绍 点击查看),根据阳性管的支数查找金黄色葡萄球菌的数目进行结果报告。
四、注意事项
在进行金黄色葡萄球菌检验的过程中,需要注意以下几点:
(1)配制Baird-Parker琼脂基础培养基时,一定要注意加入亚碲酸钾卵黄乳液时,培养基的温度不能太高,以免影响亚碲酸钾的作用,或者导致卵黄絮凝。
(2)在观察Baird-Parker平板上的菌落特征时,一定要注意金黄色葡萄球菌具有“双环”,即一圈浑浊带,外侧有一透明环。只有单环浑浊带的一般是变形杆菌。
(3)在进行血浆凝固试验时要注意:可疑菌落需同时接种在5ml的BHI肉汤中和营养琼脂上;必须使用新鲜的BHI肉汤培养物;加入BHI肉汤培养物后,要轻轻转动瓶身至混合均匀;试验应每半小时观察一次,不可直接观察第6h后的结果。一些金葡菌能够产生蛋白酶来分解纤维蛋白,而出现先凝集而后消融的情况,保证每半小时观察一次,防止因观察不及时,而误判成假阴性。
(4)观察凝固情况时,采用将西林瓶缓慢倾斜或倒置的方式。当凝固体积大于原体积一半,即可判为阳性。切记不要采用摇晃的方式进行观察!
注:本文属海博生物原创,未经允许不得转载。
上一篇:铜绿假单胞菌检验方法
下一篇:大肠菌群的快速检测方法及结果判断
